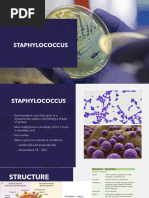

0% found this document useful (0 votes)
57 views8 pagesGram-Positive Cocci Staphylococcus CLINICAL SIGNIFICANCE
Staphylococcus aureus is the most clinically important staphylococcal species, capable of causing a wide range of human diseases. It possesses many virulence factors and has become resistant to many therapeutic agents. S. aureus is a common cause of nosocomial pneumonia, skin and soft tissue infections, and bacteremia. Diseases include superficial and deep skin infections, as well as life-threatening infections like necrotizing fasciitis. Toxin-mediated diseases include toxic shock syndrome and staphylococcal food poisoning. Coagulase-negative staphylococci like S. epidermidis are opportunistic pathogens that commonly cause infections associated with medical devices and prosthetics.
Uploaded by
sobia faryadaliCopyright
© © All Rights Reserved
We take content rights seriously. If you suspect this is your content, claim it here.
Available Formats
Download as DOCX, PDF, TXT or read online on Scribd
0% found this document useful (0 votes)
57 views8 pagesGram-Positive Cocci Staphylococcus CLINICAL SIGNIFICANCE
Staphylococcus aureus is the most clinically important staphylococcal species, capable of causing a wide range of human diseases. It possesses many virulence factors and has become resistant to many therapeutic agents. S. aureus is a common cause of nosocomial pneumonia, skin and soft tissue infections, and bacteremia. Diseases include superficial and deep skin infections, as well as life-threatening infections like necrotizing fasciitis. Toxin-mediated diseases include toxic shock syndrome and staphylococcal food poisoning. Coagulase-negative staphylococci like S. epidermidis are opportunistic pathogens that commonly cause infections associated with medical devices and prosthetics.
Uploaded by
sobia faryadaliCopyright
© © All Rights Reserved
We take content rights seriously. If you suspect this is your content, claim it here.
Available Formats
Download as DOCX, PDF, TXT or read online on Scribd
/ 8